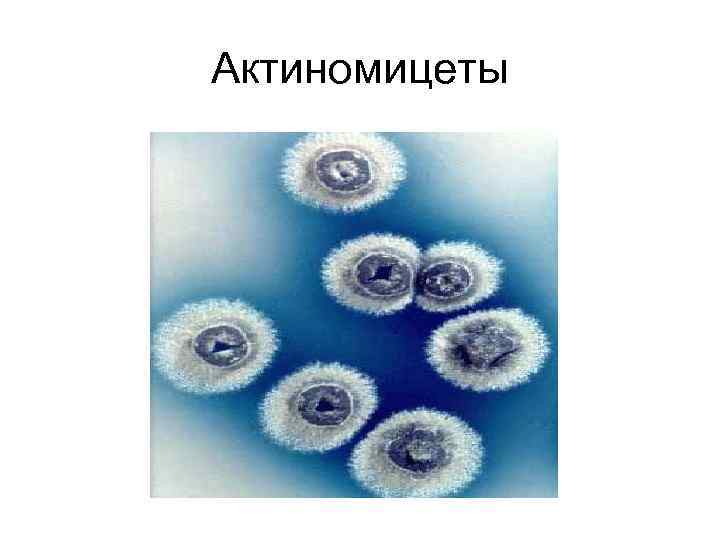
Актиномицеты

атмосфера и загрязнение.ppt
- Количество слайдов: 57

Государственное Бюджетное Образовательное Учреждение Среднего Профессионального Образования «Камчатский медицинский колледж» Атмосферный воздух, его физические и химические свойства, гигиеническое и экологическое значение Преподаватель гигиены и экологии Левенец Ольга Владимировна

План лекции • • • 1. Состав и строение атмосферы 2. Характеристика солнечной радиации 3. Микрофлора воздуха 4. Физические свойства воздуха 5. Загрязнение атмосферного воздуха 6. Защита воздушной среды от загрязнений


Строение атмосферы


Зависимость энергии излучения областей электромагнитного спектра Солнца от высоты стояния его над горизонтом Высота стояния Солнца, град У горизонта 600 В зените при 900 Энергия излучения области спектра, % Ультрафиоле Видимой Инфракрас товой ной 0 28 72 3 44 53 4 46 50

Микрофлора воздуха

Бактериологическая чистота воздуха Оценка воздуха Содержание микроорганизмов в 1 м 3 воздуха (общее микробное число) Летний период Зимний период Чистый Менее 1500 Менее 4500 Умеренно загрязненный 1500 -2500 4500 -7000 Загрязненный Более 2500 Более 7000

Стрептококки

Кишечная палочка

Клостридии

Бордетеллы коклюша
Актиномицеты

Палочки Коха

Дифтерийные палочки

Аспергиллы

Вирусы паротита

Вирусы гриппа

Вирус кори

Вирусы краснухи

Вирусы ветряной оспы

Вирус герпеса

Аденовирусы

Физические свойства воздуха • • температура - 18 -200 влажность – 40 -60% давление – 755 мм. рт. скорость движения воздуха – 0, 2 -0, 4 м/с (в помещении)

Гигиенические приборы

Анероид

Ртутный барометр

Гипсотермометр

Барограф

Газовый термометр

Термограф

Психрометр и кататермометры

Анемометры

Прибор Кротова

Газоанализаторы

Загрязнение атмосферного воздуха

Основные источники загрязнения атмосферы Естественные (природные) Пыльные бури Искусственные (антропогенные) Промышленные предприятия Транспорт Вулканическая деятельность Лесные пожары Теплоэнергетика Выветривание Отопление жилищ Разложение земных организмов Сельское хозяйство

Соотношение между естественным и антропогенным поступлением веществ в атмосферный воздух Вещество Природное поступление, т/год Антропогенное поступление, т/год Озон 2 х109 Незначительно Двуокись углерода 7 х1010 1, 5 х1010 Окись углерода - 2 х108 Сернистый газ 1, 42 х108 7, 3 х107 Соединения азота 1, 4 х109 1, 5 х107 Взвешенные вещества До 2, 2 х109 До 2, 62 х109

Выбросы антропогенных источников загрязнения Основные источники Автомобильный транспорт 90% всех загрязнений Угарный газ Окись азота Углеводороды Окись серы Авиатранспорт Теплоэлектростанции Окислы азота, разрушающие озоновый слой Сажа Зола Окислы серы Окислы азота Двуокись углерода Мышьяк Селен Окислы железа, кальция, магния Радиоактивные элементы Смолистые вещества Промышленность Железнорудная пыль Сернистый газ Окись углерода Окись азота Фенолы Окислы металлов Углеводороды Сероводород Фтористые соединения

Вредное воздействие антропогенных загрязнений на человека Острое действие Пример: действие токсических туманов Хроническое действие Специфическое: Канцерогенное Эмбриотропное Тератогенное Гонадотоксическое Мутагенное Неспецифическое: Ослабление иммунной системы Увеличение общей заболеваемости

Влияние загрязнения воздуха на здоровье людей Вещества ПДК, мг/м 3 Влияние Сернистый газ 0, 5 острые респираторные заболевания, замедленное физическое развитие, сдвиг показателей крови Двуокись азота 0, 085 изменение обмена веществ, сдвиг показателей крови, уменьшение общего белка, ускорение свертываемости крови Сероводород 1, 0 риниты, конъюнктивиты, бронхиты, головные боли, расстройства пищеварения, снижение слуха, анемии, сосудисто-вегетативные нарушения, гнойничковые заболевания Пыль 0, 05 легочные и аллергические заболевания

Поступление ксенобиотиков в организм человека ингаляционным путем • Что поступает: пыль, дым, парообразные вещества, ацетон, эфиры, бензол • Что влияет на проникновение: размер частиц, плотность, высокая растворимость в воде • Механизм проникновения: простая диффузия по градиенту концентрации • Барьер: липидная и мукоидная пленка слизистых, слой протоплазмы альвеолярных клеток, мембраны эпителия и капилляров

Средние изменения климата, связанные с загрязнением атмосферного воздуха Фактор Конденсация взвешенных частиц По сравнению с сельской местностью В 10 раз больше Газообразные загрязнения Облачность В 5 -25 раз больше На 5 -10% больше Туман зимой Туман летом Солнечная радиация Ультрафиолетовая радиация зимой Ультрафиолетовая радиация летом На 100% больше На 30% больше На 15 -20% ниже На 30% ниже На 5% ниже

Защита воздушной среды от загрязнений

Мероприятия по профилактике загрязнений атмосферного воздуха Технологические Законодательные Планировочные Санитарно-технические

Технологические создание замкнутых процессов, правильная утилизация отходов, очистка сырья от вредных примесей, замена сухих способов переработки пылящих материалов мокрыми, замена пламенного нагрева электрическим, герметизация процессов, замена прерывистых процессов непрерывными Санитарнотехнические создание очистных сооружений для улавливания пыли Законодательные федеральные и муниципальные законы ( «Об охране атмосферного воздуха» ) и постановления Планировочные учет «розы ветров» , зонирование территорий города, организация санитарно-защитных зон, озеленение населенных пунктов, планировка жилых районов

• Меры борьбы с загрязнениями складываются из осуществления государственных мероприятий и расширения научных знаний. • С целью предотвращения загрязнения атмосферы разработаны мероприятия, обеспечивающие правильное сжигание топлива, • переход на газифицированное центральное отопление, • улучшение конструкций автомобилей (переход на сжиженный газ, этиловый спирт, разработка автомобилей с электрическим двигателем).

Очистные сооружения Пылеуловители

Пылеосадочные камеры

Электрофильтры

Скрубберы

Золоуловители

Планировка застройки кварталов • Ближнюю к магистрали зону застраивают коммунально-бытовыми зданиями, далее – малоэтажные постройки и здания высокой этажности, затем – детские сады, лечебные учреждения, более требовательные к качеству воздуха. • Замкнутые застройки применяют только в городах, где ветры больших скоростей, что способствует очищению воздуха. • Промышленные районы размещают на хорошо проветриваемых территориях подветренно по отношению к жилым районам.

Роза ветров

Роль зеленых насаждений • Деревья очищают воздух от взвешенных в нем жидких и твердых частиц, поглощают вредные газы, на деревьях оседает до 72% частиц пыли и до 60% диоксида серы. • Многие виды растений выделяют фитонциды – биологически активные вещества, убивающие бактерии. • Зеленые растения регулируют микроклимат города, поглощают и снижают городской шум.

• Сернистый газ хорошо поглощает тополь, липа, клен, каштан.

• Фенолы поглощают сирень, шелковица, бузина.
атмосфера и загрязнение.ppt